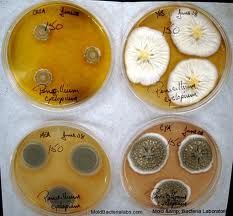
圓弧青黴 圓弧青黴

圓弧青黴
| 拉丁綱名 | Fungi Imperficti |
| 中文綱名 | 半知菌綱 |
| 拉丁目名 | Sphaeropsidales |
| 中文目名 | 殼霉目 |
| 拉丁科名 | Discellaceae |
| 中文科名 | 杯霉科 |
| 拉丁名 | Penicillium cyclopium |
| 中文名 | 圓弧青黴 |
| 定名人 | Westl. |
| 參考文獻 | Discellaceae |
識別特徵
物種性別:不清圖片說明引進來源
上海工業微生物研究所保護及保存現狀
人工保存主要用途和價值
食品加工野生馴化
家養/栽培水生陸生
陸生保護級別
未列入瀕危等級
無危菌物界(一)
| “菌物界”這個名詞是我國學者裘維蕃等於1990年提出的,並已得學術界的一定支持,這是指與動物界,植物界相併列的一大群無葉綠素,依靠細胞表面吸收有機養料,細胞壁一般還有幾丁質的真核微生物。一般包括真菌,粘菌和假菌(卵菌等)3類。 |